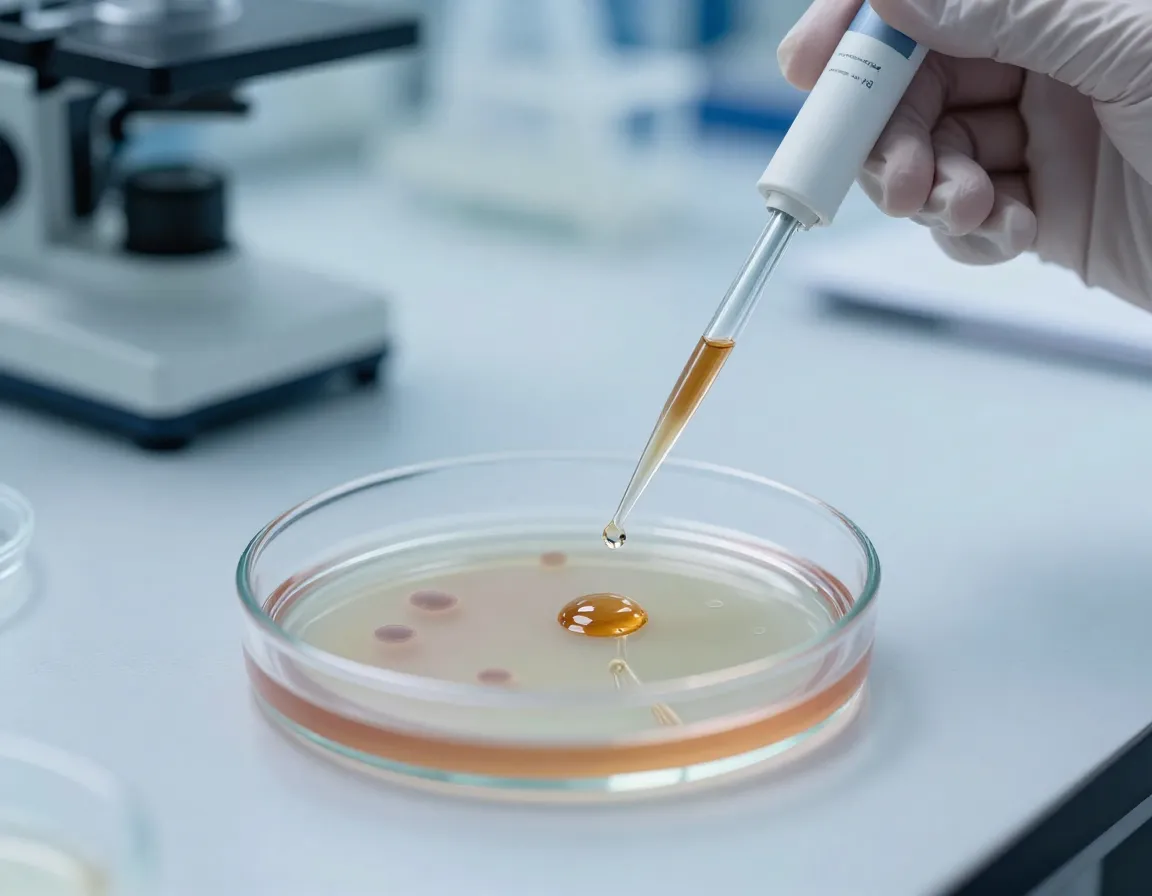
Laboratory petri dish with cell culture and cinnamon extract droplets

8 Surprising Health Benefits of Cinnamon Tea (And How to Make It)
Picture this: you’re sipping a warm, aromatic cup of tea that not only tastes like a cozy autumn morning but also works quietly behind the scenes to support your , balance your , and fight inflammation throughout your body. This isn’t just wishful thinking—it’s the remarkable reality of . While most people know cinnamon as that sweet spice that makes everything taste like the holidays, the 8 surprising of cinnamon tea (and how to make it) reveal a powerful wellness ally that’s been hiding in plain sight in your spice cabinet.

As someone who’s spent years researching remedies, I’ve discovered that cinnamon tea stands out as one of nature’s most underrated therapeutic beverages. From ancient Ayurvedic practices to cutting-edge 2026 research, this humble spice continues to surprise scientists and health enthusiasts alike with its impressive range of benefits.
Key Takeaways
- Cardiovascular Support: Cinnamon tea contains compounds that help lower and reduce harmful cholesterol levels
- Balance: Regular consumption may help improve fasting blood sugar levels and support diabetes management
- Power: The antioxidants in cinnamon tea fight chronic inflammation linked to various health conditions
- Easy Preparation: Making therapeutic cinnamon tea requires just cinnamon sticks or powder, , and 10-15 minutes of steeping time
- Type Matters: Ceylon cinnamon is safer for daily consumption than Cassia cinnamon due to lower coumarin content
The Science Behind Cinnamon’s Health Powers
Before diving into the 8 surprising health benefits of cinnamon tea (and how to make it), it’s important to understand what makes this spice so special. Cinnamon contains several bioactive compounds, including cinnamaldehyde, cinnamic acid, and cinnamophilin, which are responsible for most of its therapeutic effects [1].
One teaspoon of cinnamon powder provides 6 calories, 2 grams of carbohydrates, 1 gram of fiber, plus small amounts of calcium, iron, and potassium [1]. While these numbers might seem modest, the real magic lies in the concentration of antioxidants and compounds that become available when you steep cinnamon in hot water.
However, it’s worth noting that the National Center for Complementary and Integrative Health (NCCIH) states that “research doesn’t clearly support using cinnamon for any health condition,” and notes it’s unclear whether cinnamon supplementation is helpful for diabetes or [6]. This reminds us that while promising, cinnamon tea should complement, not replace, conventional medical treatments.
8 Surprising Health Benefits of Cinnamon Tea
1. Supports Cardiovascular Health ❤️

One of the most impressive benefits of cinnamon tea lies in its ability to support . Research from 2024 shows that cinnamon effectively prevents and treats cardiovascular diseases by lowering blood pressure and lipids [2]. The specific compounds cinnamaldehyde and cinnamophilin have been shown to:
- Lower blood pressure naturally
- Expand vascular tissue for improved circulation
- Reduce triglycerides and LDL (“bad”) cholesterol [1]
When I first learned about these cardiovascular benefits, I was amazed by how a simple cup of tea could provide such comprehensive heart support. The mechanism works by helping blood vessels relax and improving overall circulation, which can be particularly beneficial for people with mild hypertension or those looking to maintain healthy cholesterol levels.
“The compounds in cinnamon tea work synergistically to support multiple aspects of cardiovascular health, from blood pressure regulation to cholesterol management.”
2. Helps Manage Blood Sugar Levels 📊

For people dealing with prediabetes or Type 2 diabetes, cinnamon tea offers promising support. Studies indicate that cinnamon can lower fasting blood sugar levels and hemoglobin A1C in people with these conditions [1][4].
One particularly compelling 12-week study found that participants taking cinnamon supplements had better blood sugar levels both during fasting and after meals [4]. This suggests that the compounds in cinnamon may help improve insulin sensitivity and glucose metabolism.
Key blood sugar benefits include:
- Improved fasting
- Better post-meal blood sugar control
- Potential reduction in hemoglobin A1C
- Enhanced insulin sensitivity
It’s important to note that while these results are encouraging, anyone with diabetes should work with their healthcare provider before adding cinnamon tea to their routine, as it may interact with diabetes medications.
3. Provides Natural Menstrual Pain Relief 🌸

Women dealing with painful periods may find relief in their . Research shows that women who drank cinnamon tea reported significantly less menstrual pain compared to those given a placebo [1]. Additionally, cinnamon helped reduce:
- Menstrual bleeding intensity
- Nausea during menstruation
- Vomiting associated with menstrual cycles [1]
This benefit particularly resonates with me because it represents a gentle, natural approach to managing menstrual discomfort. Unlike some over-the-counter pain relievers that can cause stomach upset, cinnamon tea provides relief while also offering additional health benefits.
4. Delivers Powerful Anti-inflammatory and Antioxidant Effects 🛡️

Chronic inflammation is linked to numerous health problems, from arthritis to heart disease. Cinnamon contains cinnamaldehyde, cinnamic acid, and other compounds with potent anti-inflammatory and that may help with metabolic and chronic inflammatory conditions, including arthritis [3].
These antioxidants work by:
- Neutralizing harmful free radicals
- Reducing inflammatory markers in the body
- Supporting cellular repair processes
- Protecting against oxidative stress
The anti-inflammatory effects of cinnamon tea can be particularly beneficial for people with conditions like rheumatoid arthritis or those looking to reduce general inflammation in their bodies.
5. May Support Brain Health and Cognitive Function 🧠

While research is still in early stages, animal studies suggest that cinnamon may improve memory and learning while protecting against neurodegenerative diseases like Alzheimer’s and Parkinson’s [3][4]. However, it’s important to note that no human studies currently support prevention or treatment of these conditions [4].
The potential brain benefits may include:
- Enhanced memory formation
- Improved learning capacity
- Protection against neurodegeneration
- Better with aging
While we can’t make definitive claims about cinnamon tea preventing dementia, the preliminary research is intriguing enough to warrant further investigation.
6. Shows Promise in Cancer Research 🔬

A 2023 study found that cinnamon extract reduces oxidative stress and improves immune responses against blood cancers in animal models and cell cultures, triggering cancer cell death [2]. This research is particularly exciting because it suggests cinnamon might help the body’s natural defense mechanisms work more effectively.
Important considerations:
- Research is still in early stages
- Cinnamon is not a cure for cancer
- Further clinical studies are needed [2]
- Should never replace conventional cancer treatment
While these findings are promising, it’s crucial to understand that cinnamon tea is not a cancer treatment and should never be used as a substitute for proven medical therapies.
7. Helps Alleviate Allergy Symptoms 🌿
For those suffering from hay fever and allergic rhinitis, cinnamon offers unexpected relief. Studies have shown that cinnamon nasal spray was effective at reducing allergic rhinitis symptoms, including nasal congestion and eye tearing, with no reported side effects [4].
While drinking cinnamon tea may not provide the same direct nasal relief as a spray, the anti-inflammatory compounds can still help reduce overall allergic responses in the body. This makes cinnamon tea a gentle addition to seasonal allergy management routines.
8. Supports Overall Immune Function 💪

The combination of antioxidants, anti-inflammatory compounds, and antimicrobial properties in cinnamon tea creates a powerful immune-supporting beverage. Regular consumption may help:
- Strengthen the body’s natural defenses
- Reduce the duration of minor illnesses
- Support recovery from infections
- Maintain overall wellness
The immune-supporting effects come from cinnamon’s ability to fight oxidative stress and inflammation, both of which can weaken immune function when left unchecked.
How to Make the Perfect Cup of Cinnamon Tea
Now that you understand the impressive health benefits, let’s explore how to make cinnamon tea that maximizes both flavor and therapeutic potential. The preparation method can significantly impact the concentration of beneficial compounds you’ll receive.
Choosing the Right Type of Cinnamon
Not all cinnamon is created equal. Ceylon cinnamon, grown primarily in Sri Lanka and known as “true cinnamon,” differs significantly from Cassia cinnamon—the most common type sold in North America [2][4].
Ceylon vs. Cassia Cinnamon:
| Feature | Ceylon Cinnamon | Cassia Cinnamon |
|---|---|---|
| Coumarin Content | Very low | High |
| Safety for Daily Use | Excellent | Limited |
| Flavor Profile | Delicate, sweet | Strong, spicy |
| Cost | Higher | Lower |
| Availability | Specialty stores | Common in supermarkets |
Ceylon cinnamon contains much lower amounts of coumarin, a compound that can be harmful in large amounts [2][4]. For daily tea consumption, Ceylon cinnamon is the safer choice.
Basic Cinnamon Tea Recipe
Ingredients:
- 1-2 Ceylon cinnamon sticks (or 1/2 teaspoon Ceylon cinnamon powder)
- 1 cup (8 oz) filtered water
- Optional: honey, lemon, or ginger for flavor
Instructions:
- Boil the water in a kettle or saucepan
- Add cinnamon to your teapot or cup
- Pour hot water over the cinnamon
- Steep for 10-15 minutes for maximum benefit extraction
- Strain if using cinnamon sticks
- Add sweeteners or flavor enhancers if desired
- Enjoy while warm for best taste and comfort
Advanced Preparation Tips
For Stronger Therapeutic Effects:
- Use 2-3 cinnamon sticks per cup
- Steep for up to 20 minutes
- Cover the cup while steeping to prevent essential oils from escaping
For Better Flavor:
- Add a slice of fresh ginger
- Include a squeeze of lemon juice
- Sweeten with raw honey instead of sugar
- Try adding a pinch of cardamom or nutmeg
Batch Preparation:
- Make a large batch and store in the refrigerator for up to 3 days
- Reheat gently or enjoy cold as iced cinnamon tea
- Add fresh ingredients when reheating for best flavor
When and How Much to Drink
For optimal health benefits, I recommend:
- 1-2 cups daily for general wellness
- Morning consumption to help with blood sugar control throughout the day
- Evening consumption for relaxation and anti-inflammatory benefits
- Before meals to potentially help with blood sugar management
Important Safety Considerations:
- Start with smaller amounts to assess tolerance
- Consult healthcare providers if taking medications
- Pregnant women should limit cinnamon intake
- People with liver conditions should avoid large amounts
Maximizing the Health Benefits
To get the most from your cinnamon tea routine, consider these evidence-based strategies:
Timing Matters
Best times to drink cinnamon tea:
- 30 minutes before meals for blood sugar support
- Morning to kickstart metabolism
- Evening for anti-inflammatory benefits during sleep
- During menstruation for (women)
Enhance Absorption
Certain combinations can boost the bioavailability of cinnamon’s beneficial compounds:
- Add black pepper (tiny pinch) to increase absorption
- Include healthy fats like a small amount of coconut oil
- Pair with through lemon juice
- Drink on an empty stomach for maximum absorption
Create a Therapeutic Routine
Consistency is key for experiencing the full benefits. Consider:
- Setting daily reminders for tea time
- Preparing ingredients in advance
- Tracking how you feel over several weeks
- Adjusting timing based on your response
Potential Side Effects and Precautions
While cinnamon tea is generally safe for most people, it’s important to be aware of potential side effects and interactions:
Possible Side Effects
Common mild effects:
- Mouth irritation with excessive consumption
- Digestive upset in sensitive individuals
- Allergic reactions in rare cases
Serious concerns with high doses:
- Liver damage (primarily from Cassia cinnamon’s coumarin)
- Blood thinning effects
- Interaction with diabetes medications
Who Should Exercise Caution
Consult healthcare providers if you:
- Take diabetes medications
- Have liver conditions
- Are pregnant or breastfeeding
- Take blood-thinning medications
- Have scheduled surgery (stop 2 weeks prior)
Safe Consumption Guidelines
- Stick to 1-2 cups daily
- Choose Ceylon over Cassia cinnamon
- Start with smaller amounts
- Monitor your body’s response
- Take breaks from daily consumption periodically
Conclusion
The 8 surprising health benefits of cinnamon tea (and how to make it) reveal just how powerful this simple beverage can be for supporting overall wellness. From cardiovascular health and blood sugar management to menstrual pain relief and , cinnamon tea offers a gentle yet effective way to enhance your daily health routine.
What I find most compelling about cinnamon tea is its accessibility—this isn’t an expensive supplement or complicated treatment protocol. It’s a warm, comforting beverage that you can easily incorporate into your existing routine while potentially gaining significant health benefits.
Your next steps:
- Purchase high-quality Ceylon cinnamon sticks or powder
- Start with one cup daily to assess your tolerance
- Choose optimal timing based on your health goals
- Track your experience over 2-4 weeks
- Consult your healthcare provider if you have medical conditions or take medications
Remember, while the research on cinnamon’s health benefits is promising, it’s not a magic cure-all. The most effective approach combines cinnamon tea with other healthy lifestyle choices like balanced nutrition, regular exercise, adequate sleep, and appropriate medical care.
As you embark on your cinnamon tea journey, pay attention to how your body responds. Some people notice improvements in energy levels within days, while others may see changes in blood sugar or inflammation markers over weeks or months. The key is consistency and patience as you allow this ancient remedy to work its gentle magic in your modern life.
Start brewing your first cup today, and discover for yourself why cinnamon tea has been treasured for centuries as both a delicious beverage and a powerful ally for health and wellness.
References
[1] Health Benefits Cinnamon Tea – https://www.webmd.com/diet/health-benefits-cinnamon-tea
[2] medicalnewstoday – https://www.medicalnewstoday.com/articles/318386
[3] The Health Benefits Of Cinnamon – https://naturalhealthresearch.org/the-health-benefits-of-cinnamon/
[4] Benefits Of Cinnamon – https://www.goodrx.com/well-being/diet-nutrition/benefits-of-cinnamon
[5] Index – https://sisleducation.stanford.edu/index.html?p=cinnamon-and-clove-water-benefits-in-everyday-2026-life-what-this-spiced-drink-can-and-can-t-do-for-your-health-6988c98161b6d
[6] Cinnamon – https://www.nccih.nih.gov/health/cinnamon
[7] Cinnamon Supplements – https://globalcitieshub.org/en/xzdnewsp/Cinnamon-supplements-weight-loss
